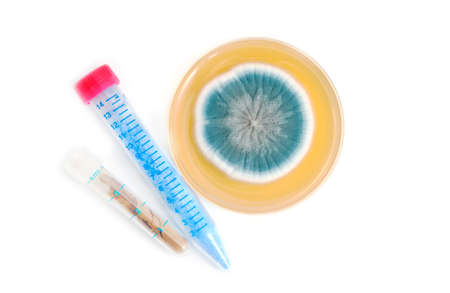
chemical compounds in tube and fungi on agar plate over white backgroundの写真素材

写真素材 - chemical compounds in tube and fungi on agar plate over white background
作品情報
chemical compounds in tube and fungi on agar plate over white background
- ID:23454074
- 作品種別:写真
- 作者名:Olha Rohulya
キーワード
- Penicillium
- Petri dish
- agar
- agar plate
- antibiotics
- assay
- bacteria
- biochemistry
- biotechnology
- blue
- brown
- chemical
- chemistry
- close up
- closeup
- compound
- cure
- drug
- education
- experiment
- experimental
- genetics
- isolated
- laboratory
- medical
- medicine
- medicine
- microbiology
- microorganisms
- penicillin
- powder
- research
- science
- scientific
- study
- tuve
- white
- white background
- fungi
類似作品
Slant tubes and...
Gloved hand hol...
chemical formul...
A close-up of l...
chemical formul...
Structural chem...
A close-up of l...
Mold and other ...
A detailed view...
Detail to micro...
A tiny, otherwo...
Macro shot of e...
Generative AI F...
Closeup of Mold...
Microdosing Con...
A cluster of vi...
Mushrooms growi...
AI Generated. C...
Coral Texture D...
Chemical formul...
Nurturing Oyste...
A captivating c...
Scientist hand ...
Mushroom in sci...
Mushrooms growi...
Close-up of cor...
Colorful waterc...
Microdosing, gr...
background made...
A detailed view...
Close up of dew...
A gloved hand h...
Close-up of a g...
Mushroom on tre...
macra photograp...
Magic Mushrooms...
aspergillus mol...
Orange mushroom...
Moss and lichen...
mold culture sl...
the medical eff...
chemical formul...
Micro Dose of P...
Mineral stone c...
A macro photogr...
Closeup of beau...
this stunning p...
Ganoderma Lucid...
the effect of p...